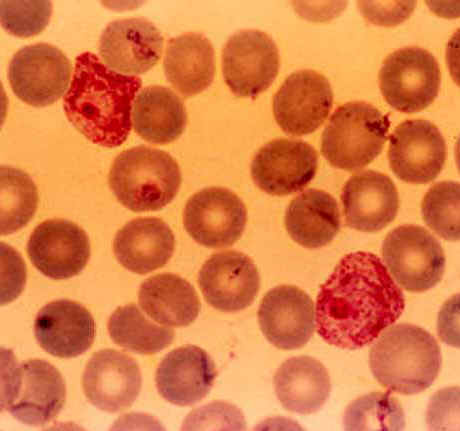
Glóbulos rojos y Plasmodium falciparum

|
PROTOZOOS
Los
protozoos son seres eucariotas (con núcleo
celular definido), unicelulares y
heterótrofos (se alimentan de materia
orgánica). Suelen ser de vida libre,
aunque existen grupos que son parásitos.
Podemos distinguir distintos tipos de
protozoos si observamos su estructura. Estos
grupos son:
Flagelados
Son
protozoos que para moverse utilizan flagelos.
Son los protozoos más primitivos. La
mayoría de los flagelados tienen vida
libre, pero hay algunos que son
parásitos. Uno famoso es el Trypanosoma
gambiense. Probablemente el nombre
no te suena de nada, pero seguro que
has oído hablar de la enfermedad
del sueño. La transmite la mosca
tse-tse, ya que el Trypanosoma vive en
su boca.
|
|
 |
|
 |
Ciliados
Son protozoos que utilizan cilios
para moverse. Los cilios son pequeñas
estructuras que la célula mueve a modo de
remos. Son seres que viven libres en el agua
dulce.
|
|
Rizópodos
Son protozoos que se mueven
emitiendo prolongaciones de su cuerpo y
deslizándose sobre la superficie sobre la
que viven. Estas prolongaciones se llaman pseudópodos,
y funcionan como falsos pies. Pueden vivir
en aguas dulces o ser parásitos.
|

|
|
Esporozoos
Son protozoos inmóviles.
Todos los individuos de este grupo son
parásitos. Uno famoso es el Plasmodium
falciparum. Produce la enfermedad
llamada malaria, o paludismo.
Esta enfermedad es la principal causa de
muerte en algunos países africanos, del
Sudeste asiático y Sudamérica.
|
 |
|
|